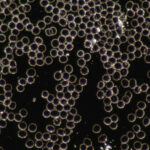

Was ist Dunkelfeld?
Dunkelfelddiagnostik ist eine Variante der normalen Lichtmikroskopie. Beim Dunkelfeldmikroskop werden die Objekte seitlich beleuchtet und erscheinen hell. Der Hintergrund bleibt dabei dunkel – daher auch der Name Dunkelfeldmikroskopie.
Mit Hilfe des Dunkelfeldmikroskops lassen sich Konturen von Objekten besonders gut erkennen. So können wir die Strukturen des lebendigen Blutes analysieren und Rückschlüsse auf die Vitalität der roten und weißen Blutkörperchen und die Qualität des Blut- und Körpermilieus ziehen.
Ohne dass eine vorherige Färbung notwendig ist, können durchsichtige und kontrastarme Objekte untersucht werden. Bei der normalen Durchlichtmikroskopie ist das nicht ausreichend möglich.
Zur Untersuchung genügt bereits ein Tropfen Blut, der auf einen Objektträger aufgebracht wird.
Was sieht man mit ihr?
Mit dieser Methode erfolgt hauptsächlich eine qualitative Beurteilung des Blutes. Aussehen, Aktivität und Funktionstüchtigkeit insbesondere der roten Blutkörperchen (Erythrozyten), aber auch anderer Strukturen im Blut werden bewertet. Auch bestimmte Bakterien und Parasiten, wie etwa die Borrelien, sind mit dem Dunkelfeldmikroskop sichtbar.
So lassen sich Aussagen über das innere Milieu, das Immunsystem und Organbelastungen treffen. Dabei können Entwicklungen zu einem Krankheitsbild erkannt werden, noch bevor diese körperliche Symptome verursachen oder in einem herkömmlichen Blutbild sichtbar wären.
Somit ist die Dunkelfelddiagnostik zur Prävention von Krankheitsausbrüchen bzw. zur frühzeitigen Diagnostik bei bestimmten Krankheitstendenzen sehr wertvoll und zudem für den Tierhalter nachvollziehbar: Denn die Strukturen des Blutes können Sie live am Bildschirm mitverfolgen und die Veränderungen während und nach der Therapie mit eigenen Augen sehen.